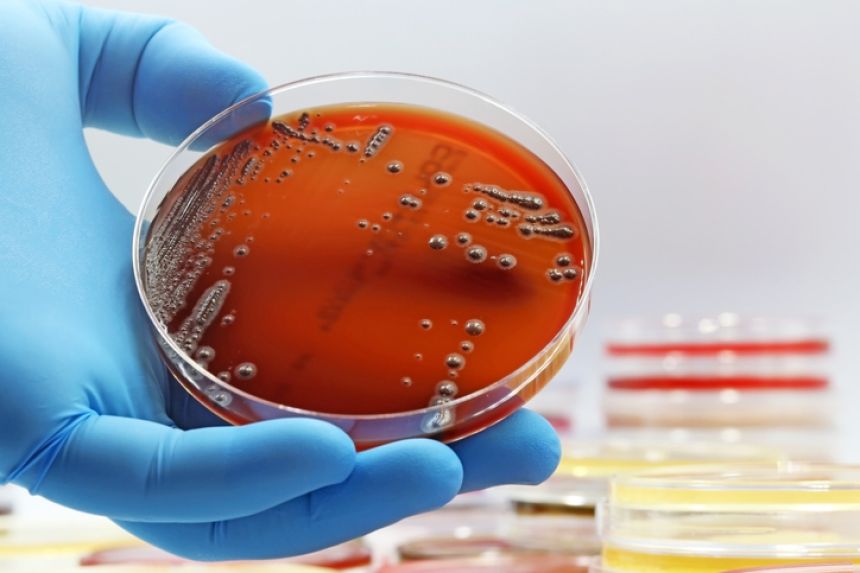

この画像を大きなサイズで見る
この画像を大きなサイズで見る中国の宇宙ステーション「天宮」で未知の細菌が発見されたそうだ。
幸か不幸か、どうやら宇宙の果てから地球に飛来した侵略者というわけではなそうだ。だが細菌が宇宙でも存在できるというその事実は、宇宙時代にこの小さな生物が地球の外へと移住することを予防するのは難しいことを示している。
それは宇宙飛行士の健康をリスクにさらすだけでなく、今後の地球外生命探査に影を投げかけるかもしれない。
中国の宇宙ステーションで未知の細菌を発見
国際宇宙ステーション(ISS)の約20%の大きさである中国の天宮宇宙ステーションもまた、物理学からバイオテクノロジーに至るまで様々な分野の実験を行っている。これまでにおよそ180件の科学実験が天宮で実施されてきた。
そのうちの1つ、「居住区マイクロバイオーム計画」では、神舟航天生物科技グループ(Shenzhou Space Biotechnology Group)をはじめとするチームが、3つのモジュールから成る天宮の内部を2回にわたって綿棒で採取するという調査を行った。
するとそこに未知の細菌が潜んでいることが判明したのである。
発見場所にちなみ、「ニアリア・ティアンゴンゲンシス(Niallia tiangongensis)」(天宮は中国語でtiangongと発音される)と名付けられた新種の細菌は、地球外から飛来した謎の生命体というわけではない。
地球の土の中には「ニアリア・サーキュランス(Niallia circulans)」という細菌が存在するが、ニアリア・ティアンゴンゲンシス(以下N.ティアンゴンゲンシス)はその近縁種だと考えられている。
ニアリアは、バシラス科に属するグラム陽性の真正細菌である。
この新種がもともと地上に存在し、どこからか紛れ込んだのか、それとも宇宙で進化したのか、確かなことはわからない。
だがN・サーキュランスが傷口感染することからも、宇宙ステーション内の細菌の存在は、宇宙飛行士の健康に対するリスクであると、論文で説明されている。
「長期の宇宙ミッションにおける微生物の特性を理解することは、宇宙飛行士の健康を守り、宇宙船の機能を維持するうえで不可欠である」
この画像を大きなサイズで見る
この画像を大きなサイズで見るNASAのクリーンルームでも新種細菌を発見
一方、NASA、サウジアラビア、インドの科学者らによる共同研究では、NASAが2007年に打ち上げた火星探査機「フェニックス」のミッションに用いたクリーンルームにおいて、26種の未知の細菌が発見された。
この研究は、微生物が宇宙空間という極限環境をどの程度生き延びられるかを調査することを目的として行われ、研究結果は学術誌『Microbiome』に発表された。
 この画像を大きなサイズで見る
この画像を大きなサイズで見る地球由来の細菌のせいで、地球外生命が汚染される可能性
現在までに20以上の探査機やローバーが火星へ送られていることから、地球由来の微生物が既に火星に到達している可能性は高く、火星に本来存在するかもしれない地球外生命(微生物)の探索に支障を来す恐れがある。
こうした細菌は、宇宙飛行士の健康の問題だけではなく、地球外生命の発見を待ち望む好奇心旺盛な人々にとっても嬉しくないものだ。
それらがそこで生存しているかどうかは不明だ。だが、仮にそれが火星を汚染したとすれば、火星の生命(存在するならの話だ)とどう区別すればいいのか? これは地球外生命探査ミッションにおいて由々しき問題となる。
そもそもNASAの研究もそのリスクを知ることが目的だった。
サウジアラビア、キング・アブドゥッラー科学技術大学アレクサンドル・ロサド氏は、「宇宙探査ミッションにおける極限環境生物の移送リスクを評価し、どのような微生物が生存可能かを特定することは、意図しない惑星の微生物汚染を防ぐために極めて重要である」と述べている。
中国の研究は『International Journal of Systematic and Evolutionary Microbiology』(2025年3月3日付)、NASAなどの研究は『Microbiome』(2025年5月12日付)に掲載された。
References: Tough microbes found in NASA cleanrooms hold clues to space survival and biotech / An Unknown Microbe Snuck Onto China's Space Station. Could It Infect the Universe?

















テラフォーミングと地球外汚染は解釈が違うだけで実質同じ事なのでしょう
宇宙に行くのに人間そのた他あらゆるものにくっついてる細菌を100%殺してから行くのか?
宇宙空間でも死なないものをなるべく排除していかないと、現地では侵略的外来種として先方の害になりそうです
惑星探査機関連は一応規定があって、完成した衛星を一度蒸して滅菌したりと、様々な方法で滅菌したりしている
確か宇宙空間で一時的に暴露させる規定もあった気がする
あとクリーンルームでの製造も精密機械のためでもあるけど、細菌よけの意味もある
そのクリーンルームで細菌発見はさすがに困っただろうなと
しかし、低軌道での新型細菌は本当に人間が運んだものだけだろうかという疑問も感じる
ライアン・レイノルズやら真田広之やらジェイク・ギレンホールを養分にしたタコエイリアンを思い出した。
っても成層圏からカビやキノコの胞子とか
ウィルスが宇宙に飛散してんだがな
そんなもんはあまねく宇宙線で即死するが
そういうことじゃあないんだよ
ほんの序章にすぎなかったのじゃ…
リリィキャットに出てきた人食いバクテリアとかあるのかな